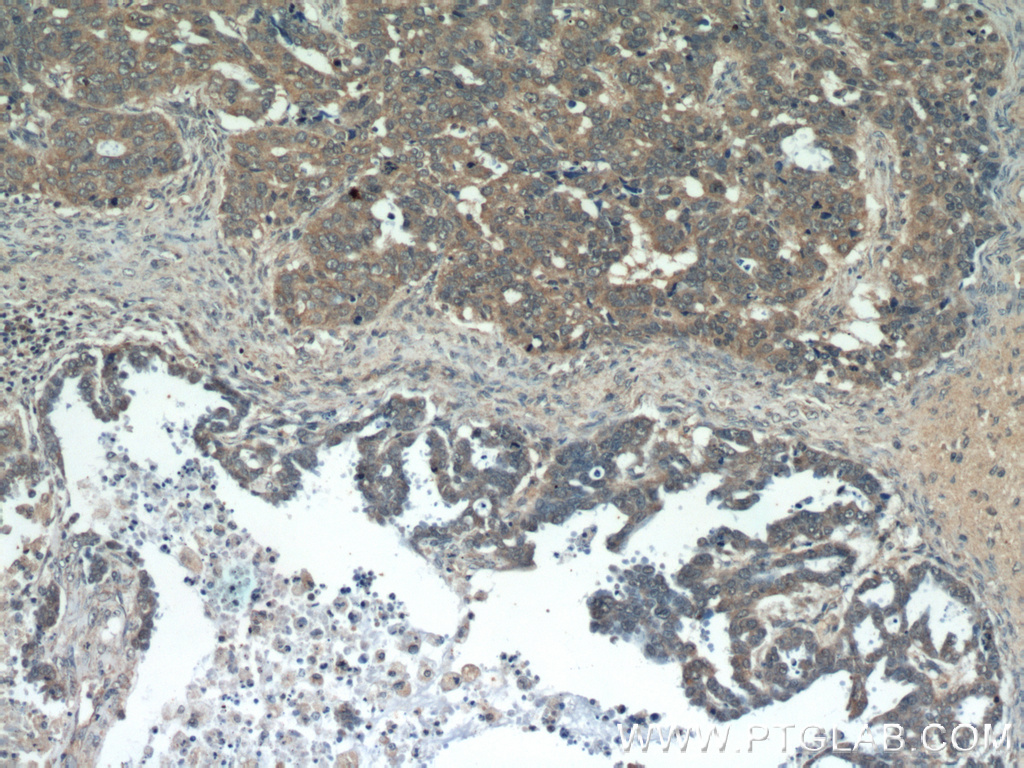

验证数据展示
经过测试的应用
| Positive WB detected in | HeLa cells, human plasma, mouse liver tissue, MCF-7 cells, PC-3 cells |
| Positive IHC detected in | human prostate cancer tissue, human lung cancer tissue, human ovary tumor tissue Note: suggested antigen retrieval with TE buffer pH 9.0; (*) Alternatively, antigen retrieval may be performed with citrate buffer pH 6.0 |
| Positive IF/ICC detected in | HeLa cells |
推荐稀释比
| 应用 | 推荐稀释比 |
|---|---|
| Western Blot (WB) | WB : 1:2000-1:10000 |
| Immunohistochemistry (IHC) | IHC : 1:50-1:500 |
| Immunofluorescence (IF)/ICC | IF/ICC : 1:200-1:800 |
| It is recommended that this reagent should be titrated in each testing system to obtain optimal results. | |
| Sample-dependent, Check data in validation data gallery. | |
发表文章中的应用
| WB | See 6 publications below |
产品信息
13419-1-AP targets GSK3A in WB, IHC, IF/ICC, ELISA applications and shows reactivity with human, mouse, rat samples.
| 经测试应用 | WB, IHC, IF/ICC, ELISA Application Description |
| 文献引用应用 | WB |
| 经测试反应性 | human, mouse, rat |
| 文献引用反应性 | human, mouse |
| 免疫原 |
CatNo: Ag4168 Product name: Recombinant human GSK3A protein Source: e coli.-derived, PGEX-4T Tag: GST Domain: 134-483 aa of BC027984 Sequence: YQARLAETRELVAIKKVLQDKRFKNRELQIMRKLDHCNIVRLRYFFYSSGEKKDELYLNLVLEYVPETVYRVARHFTKAKLTIPILYVKVYMYQLFRSLAYIHSQGVCHRDIKPQNLLVDPDTAVLKLCDFGSAKQLVRGEPNVSYICSRYYRAPELIFGATDYTSSIDVWSAGCVLAELLLGQPIFPGDSGVDQLVEIIKVLGTPTREQIREMNPNYTEFKFPQIKAHPWTKVFKSRTPPEAIALCSSLLEYTPSSRLSPLEACAHSFFDELRCLGTQLPNNRPLPPLFNFSAGELSIQPSLNAILIPPHLRSPAGTTTLTPSSQALTETPTSSDWQSTDATPTLTNSS 种属同源性预测 |
| 宿主/亚型 | Rabbit / IgG |
| 抗体类别 | Polyclonal |
| 产品类型 | Antibody |
| 全称 | glycogen synthase kinase 3 alpha |
| 别名 | Serine/threonine-protein kinase GSK3A, GSK-3 alpha, GSK 3 alpha, Glycogen synthase kinase-3 alpha, EC:2.7.11.26 |
| 计算分子量 | 483 aa, 51 kDa |
| 观测分子量 | 51 kDa |
| GenBank蛋白编号 | BC027984 |
| 基因名称 | GSK3A |
| Gene ID (NCBI) | 2931 |
| RRID | AB_2247995 |
| 偶联类型 | Unconjugated |
| 形式 | Liquid |
| 纯化方式 | Antigen affinity purification |
| UNIPROT ID | P49840 |
| 储存缓冲液 | PBS with 0.02% sodium azide and 50% glycerol, pH 7.3. |
| 储存条件 | Store at -20°C. Stable for one year after shipment. Aliquoting is unnecessary for -20oC storage. |
背景介绍
Glycogen synthase kinase-3 alpha (GSKA) is one of the two functional isoforms encoded by the GSK gene and
acts as a tumor suppressor through its kinase function, targeting many different proteins.
What is the molecular weight of GSKA?
51 kDa. GSKA is a protein serine kinase composed of 483 amino acids and the catalytic domain shares a high
degree of homology with GSKB, although they are encoded on separate genes.
What is the function of GSKA?
Constitutively expressed across all tissues, GSKA has a large number of target proteins and is therefore involved
in many different pathways (PMID: 19923896). It was first identified as a regulator of glycogen metabolism, as
GSK3A phosphorylates the enzyme glycogen synthase, thereby inhibiting glycogenesis, the conversion of glucose
into glycogen (PMID: 6249596). It has since been shown to interact with many other proteins and is one of the
kinases with most substrates in the cell, with roles in cell cycle progression, proliferation, differentiation, and
apoptosis (PMID: 17570479; PMID: 11563964). Typically, GSKA negatively regulates its downstream substrates,
often tagging proteins for ubiquitination. It has important roles in the Wnt and PI3K signaling pathways.
What is the role of GSK3A in neurodegenerative disease?
GSK3A is known to interact with beta-amyloid and tau, proteins that aggregate in areas of the neuronal system
as part of the pathology of neurodegenerative diseases such as Alzheimer's disease. It has been shown that
GSK3A causes abnormal phosphorylation of the microtubule-binding protein tau in a way that reflects the
pathology of Alzheimer's disease (PMID: 1334849; PMID: 1336152). GSKA has also been shown to process
amyloid precursor protein to beta-amyloid, another protein that forms the inclusion bodies, or Lewy bodies,
that are one of the hallmarks in Alzheimer's (PMID: 1276154). Another protein involved in the pathology of
Alzheimer's is α-synuclein, which is known to be a substrate for GSK-3β phosphorylation (PMID: 24681994).
实验方案
| Product Specific Protocols | |
|---|---|
| IF protocol for GSK3A antibody 13419-1-AP | Download protocol |
| IHC protocol for GSK3A antibody 13419-1-AP | Download protocol |
| WB protocol for GSK3A antibody 13419-1-AP | Download protocol |
| Standard Protocols | |
|---|---|
| Click here to view our Standard Protocols |
发表文章
| Species | Application | Title |
|---|---|---|
Neuropsychopharmacology Upregulation of GSK3β Contributes to Brain Disorders in Elderly REGγ-knockout Mice. | ||
Front Cell Dev Biol A GSK3-SRF Axis Mediates Angiotensin II Induced Endothelin Transcription in Vascular Endothelial Cells. | ||
iScience MYCT1 alters the glycogen shunt by regulating selective translation of RACK1-mediated enzymes. | ||
Pathol Oncol Res Knockdown of Sox2 Inhibits OS Cells Invasion and Migration via Modulating Wnt/β-Catenin Signaling Pathway. | ||
World J Diabetes Exploring the targets and molecular mechanism of glycyrrhetinic acid against diabetic nephropathy based on network pharmacology and molecular docking |